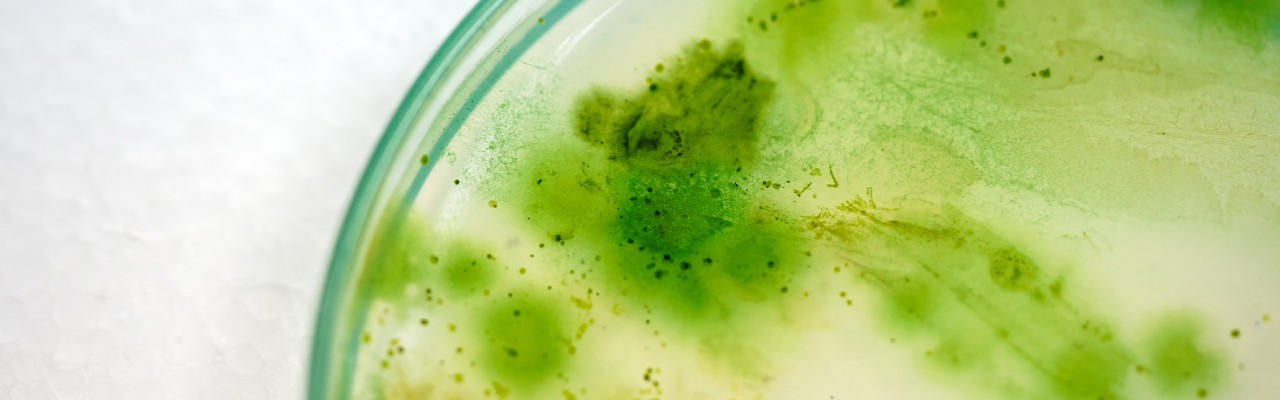

What are cyanobacteria?
The management and control of cyanobacteria in aquatic environments to meet legislation requires the implementation of monitoring programs.
Foto: iStock
Cyanobacteria are believed to be the first photosynthesizing microorganisms to inhabit the planet. They have great phenotypic and ecological plasticity, with possibilities of adaptation to the most diverse environments and regions, being considered cosmopolitan because they have wide ecological value.
Under natural conditions cyanobacteria coexist in a balanced way with other groups of aquatic organisms. However, the increased load of nutrients in the system can result in an increasing dominance of cyanobacteria, leading to the formation of blooms. Thus, associated with the physical and chemical parameters of the water, cyanobacteria act as indicators of pollution in the aquatic environment.
In the latter, there has been a significant increase in cyanobacterial blooms, with the presence of cyanotoxins and other compounds, including substances that cause taste and odor. Due to the potential risks to health and the preservation of aquatic life, this issue is gaining space in national legislation. The management and control of cyanobacteria in aquatic environments to comply with legislation requires the implementation of monitoring programs.